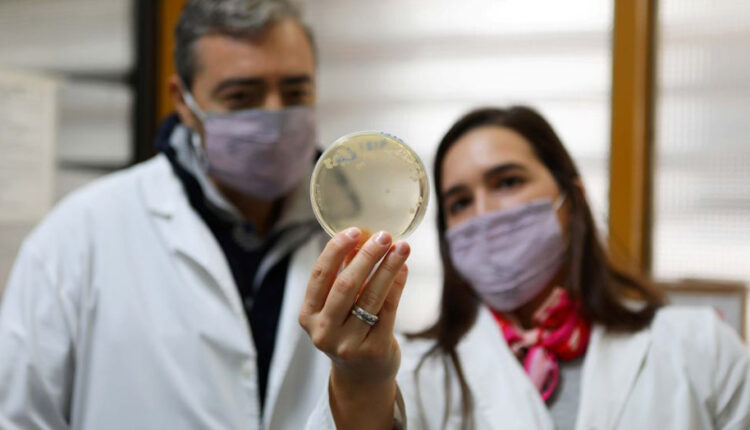
CONICET: PROPONEN REUTILIZAR DESECHOS DE LA PRODUCCIÓN DE QUESOS

A partir del suero remanente de la industria láctea se podría generar bioetanol y sustancias beneficiosas para la salud. Es un trabajo de investigadores del CONICET en colaboración con colegas de Brasil.
Al concluir los procesos de producción de la industria alimenticia se generan desechos que aún mantienen características que los hacen aprovechables porque siguen siendo ricos en sustancias capaces de ser recuperadas y utilizadas para la generación de otros productos. Esos procedimientos de recuperación gozan de gran popularidad a nivel mundial porque la reutilización de esos subproductos trae aparejado un beneficio extra: la reducción de la tasa de descarte y, consecuentemente, del impacto ambiental, ya que se trata de sustancias contaminantes. En un artículo publicado recientemente en la revista científica Applied Microbiology and Biotechnology, un equipo de investigadores del CONICET y la Universidad Estatal de Campinas (UNICAMP), Brasil, propone una nueva estrategia de biorrefinería basada en el uso del lactosuero, remanente de la elaboración de quesos, como materia prima para la obtención de bioetanol –de potencial uso como combustible ecológico–, proteínas y levaduras probióticas.
“El lactosuero contiene una proporción de las proteínas solubles de la leche, así como la mayor parte de la lactosa y del calcio presente en la leche cruda. Es un remanente generado en cantidades importantes, representa entre el 85 y el 90 por ciento del volumen de la leche empleada para hacer queso y contiene el 55 por ciento de sus nutrientes, lo que lo vuelve un efluente industrial altamente contaminante, y esto hace que exista un gran interés por encontrarle usos alternativos con el fin de absorber las grandes cantidades que generan las industrias queseras”, comenta Martín Rumbo, investigador del CONICET y director del Instituto de Estudios Inmunológicos y Fisiopatológicos (IIFP, CONICET-UNLP), y añade: “Se calcula que en Argentina casi el 50 por ciento del lactosuero es generado por pequeñas industrias y queserías artesanales, y luego es descartado o usado para fines de bajo valor agregado, como la alimentación animal. Por eso existe el interés de buscar alternativas para su conversión en productos de mayor valor”.
La estrategia para revalorizar el suero de quesería surgió en el marco de la tesis doctoral de la becaria del CONICET Dolores Pendón, del Centro de Investigación y Desarrollo en Criotecnología de Alimentos (CIDCA, CONICET-UNLP-CICPBA), sobre la base de la trayectoria y experiencia que ambos institutos tienen en el estudio de las propiedades probióticas –beneficiosas para la salud– de los microorganismos del kéfir, un producto lácteo surgido de la fermentación de levaduras y bacterias, de consistencia similar a la del yogur.
“En el marco del proyecto de kéfir, ya habíamos caracterizado distintas cepas de la levadura Kluyveromyces marxianus que presentan propiedades muy interesantes para su aplicación en una biorrefinería”, describe Graciela Garrote, investigadora del CONICET en el CIDCA y también autora del trabajo, y enumera: “Sus altas tasas de crecimiento, algo importante para la producción de biomasa; su capacidad de crecer a altas temperaturas, incluso por encima de los 45 grados centígrados, implica un bajo riesgo de contaminación y el ahorro de energía durante la fermentación, ya que exige menos refrigeración; y, como valor añadido, tiene características probióticas, incluyendo la tolerancia al ácido y las sales biliares, la supervivencia al paso a través del tracto gastrointestinal, y la capacidad inmunomoduladora y protectora frente al estrés oxidativo”.
Para el nuevo proyecto, los investigadores estudiaron 30 cepas de la levadura y pudieron seleccionar aquellas capaces de fermentar la lactosa presente en el suero y de resistir a las condiciones industriales de fermentación, proceso que implica la reutilización de las levaduras empleadas en un lote de fermentación para fermentar el siguiente pasando por etapas de sanitización por agregado de ácidos. “Comprobamos que K. marxianus tiene una excelente capacidad para ser empleada en la fermentación del lactosuero y algunas de sus cepas alcanzan una eficiencia mayor al 90 por ciento en la transformación de lactosa en bioetanol. Asimismo, tras ese proceso mantiene sus propiedades probióticas: en las pruebas in vitro vimos que tiene la capacidad de sobrevivir al paso por el tracto gastrointestinal y de modular la respuesta inmune innata del epitelio intestinal; y, además, en un modelo animal, una de las cepas permitió proteger contra el daño causado por colitis aguda. Es decir, el excedente de biomasa de levadura obtenido puede ser potencialmente comercializado como probiótico”.
Asimismo, los investigadores destacan que el mismo rendimiento y propiedades se mantienen empleando como sustrato de fermentación tanto el suero como el permeado de suero desproteinizado, proceso que permitiría separar y recuperar las proteínas del lactosuero como otro subproducto distinto y de alto valor agregado. “Es decir que proponemos un concepto de una biorrefinería muy versátil, en base a un proceso integrado con capacidad de producción de tres productos de valor agregado: bioetanol, concentrado proteico y levadura probiótica”, subrayan. Cabe destacar que actualmente el equipo se encuentra trabajando en el desarrollo a mayor escala y la transferencia de la tecnología al sector productivo, y además en la solicitud de una patente de invención en Argentina y Brasil a nombre de las tres instituciones implicadas: el CONICET, la UNICAMP y la Universidad Nacional de La Plata (UNLP).